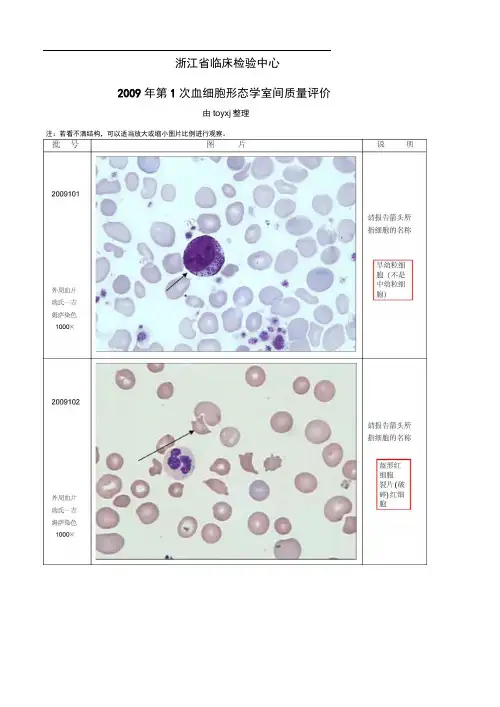

临床检验血涂片图谱
- 格式:doc
- 大小:15.20 MB
- 文档页数:29

临床医学检验技术(中级)高频考点四角的四个大方格为白细胞的计数区域,中间大方格被划分成25个中方格,【参考区间】成年:男性120~160g/L 女性110~150g/L三、红细胞形态检查【检验原理】显微镜法和血液分析仪法。
【临床意义】正常的红细胞形态为:五、红细胞平均指数红细胞平均指数包括:MCV、MCH、MCHC 【计算方法】六、网织红细胞计数【参考区间】成人:0.5%~1.5%新生儿 2.0%~6.0%【临床意义】RET是介于晚幼红细胞和成熟红细胞之间的过渡细胞,胞质中残存的RNA 经活体染料(新亚甲蓝或煌焦油蓝)染色后,形成蓝色或紫色的点粒状或丝网状沉淀物。
RET的分型• Ⅰ型丝球型:仅存在于骨髓中• Ⅱ型网型:大量存在于骨髓中,极少见于外周血• Ⅲ型破网型:少量存在于外周血• Ⅳ型点粒型:主要存在于外周血检测目的:评价骨髓的增生能力且可以判断贫血的类型:• RET增多:骨髓造血功能旺盛,见于各种增生性贫血,尤其是溶贫。
• RET减少:表示无效红细胞造血,见于非增生性贫血和慢性贫血,如缺铁贫、巨幼贫、再障等。
• 【检测方法】Miller窥盘计数法RET百分率=大方格内RET数/(小方格内RET数*9)七、嗜碱性点彩红细胞【参考区间】<0.03%【检验原理】嗜碱性点彩红细胞为不完全成熟的红细胞,胞质内残存的核酸变性、聚集形成颗粒,经亚甲蓝染色,细胞内可见到深染的颗粒;但以Wright染色,则在粉红色的胞质内出现蓝黑色颗粒。
其增高对慢性金属中毒具有辅助诊断价值。
主要见于铅、汞等重金属中毒。
八、红细胞沉降率测定五、脂酶与脂质转运蛋白1、LPL(脂蛋白脂肪酶)1)合成部位:几乎所有的实质性组织2)存在部位:全身毛细血管内皮细胞表面LPL受体上3)功能:催化CM、VLDL中甘油三酯水解,使之逐渐变为分子量较小的残骸颗粒4)激活剂:ApoCⅡ5)抑制剂:ApoCⅢ6)由肝素释放入血2、HL(肝脂酶)1)存在部位:存在于肝脏和肾上腺血管床内皮细胞中2)功能:继续LPL的工作;参与IDL向LDL转化的过程3)由肝素释放入血3、LCAT(卵磷脂胆固醇脂酰转移酶)1)合成部位:肝合成释放入血吸附在HDL分子上2)功能:催化血浆中胆固醇酯化2)最优的底物:新生的HDL,可使新生HDL转变为成熟的HDL3)激活剂:(辅助因子)Apo AⅠ第四章尿液标本采集和处理一、尿液标本类型:标本采集时间应用范围类型二、特殊尿标本1、尿三杯试验:用于泌尿系统出血部位的定位和尿道炎的诊断。

浙江省临床检验中心2009年第1次血细胞形态学室间质量评价由toyxj整理2010年第1次浙江省医院检验科血细胞形态学室间质量评价 注:若看不清结构,可以适当放大图片比例进行观察。
浙江省临床检验中心2010年第2次血细胞形态学室间质量评价 注:若看不清结构,可以适当放大图片比例进行观察。
2011年第1次浙江省医院检验科血细胞形态学室间质量评价 注:若看不清结构,可以适当放大图片比例进行观察。
2011年第2次浙江省医院检验科血细胞形态学室间质量评价 注:若看不清结构,可以适当放大图片比例进行观察。
2012年第1次浙江省医院检验科血细胞形态学室间质量评价 注:若看不清结构,可以适当放大图片比例进行观察。
2012年第2次浙江省医院检验科血细胞形态学室间质量评价 注:若看不清结构,可以适当放大图片比例进行观察。
2013年第1次浙江省医院检验科血细胞形态学室间质量评价注:若看不清结构,可以适当放大图片比例进行观察。
图片2013年第2次浙江省医院检验科血细胞形态学室间质量评价 注:若看不清结构,可以适当放大图片比例进行观察。
2014年第1次浙江省医院检验科血细胞形态学室间质量评价注:若看不清结构,可以适当放大图片比例进行观察。
批 号图 片说 明2014101外 周 血涂片 瑞氏—吉 姆萨染色 1000×请报告箭头所 指“细胞”名称编码2014102外 周 血涂片 瑞氏—吉 姆萨染色 1000×请报告箭头所 指“细胞”名称编码2014103骨髓涂片 瑞氏—吉 姆萨染色 1000×请报告箭头所指“细胞”名称编码靶形红细胞巨型骨髓瘤细胞2014年第2次浙江省医院检验科血细胞形态学室间质量评价 注:若看不清结构,可以适当放大图片比例进行观察。
2015年第1次浙江省医院检验科血细胞形态学室间质量评价 注:若看不清结构,可以适当放大图片比例进行观察。
2015年第2次浙江省医院检验科血细胞形态学室间质量评价注:若看不清结构,可以适当放大图片比例进行观察。

十分钟外周血涂片全了解!听说小伙伴们最近在看外周血涂片?显微镜下一片片的细胞究竟都是些什么?开局抽到SSS李逍遥战力无敌广告以前学习过的正常的细胞形态都已经忘记了?!不要慌,十分钟了解外周血图片!外周血涂片镜检的基本知识血液,是人体的一面镜子,动态反映了机体造血、营养、免疫等多方面的状态。
要了解患者的血细胞,外周血涂片镜检无疑是最经济、最快速的手段。
但在今天,即使是血液科,亲自动手镜检的临床医生也已少之又少。
鉴于血细胞形态学的专业性,方便临床医生判读检验结果,促进沟通,在此向读者简要介绍外周血涂片镜检的基本知识。
适用范围对于有发热待查、贫血、出血、肝脾及外周淋巴结肿大等患者,及其他需要在血常规机检项目外检查血细胞数量与形态的患者均适用。
样本采集与制片展开剩余88%成年患者常于肘静脉处采血,儿童患者也可以使用采集自指尖或足跟的末梢血样本。
血液应以EDTA-K2抗凝(紫色抗凝管)。
此外,使用肝素锂&肝素钠抗凝的绿管不适用,因其常导致镜下白细胞聚集,且易出现蓝色的背景,干扰观察;含枸橼酸钠的黑管(血沉管)和蓝管(血凝管)也不常规使用。
制片常采用薄血膜法,易于制备、细胞形态舒展容易观察,但检查疟原虫、锥虫、微丝蚴等血液寄生虫时厚血膜制片更佳。
染色一般使用瑞氏(Wright)染色,其中偏碱性的亚甲蓝能结合于核酸分子和酸性蛋白质,使这些结构呈蓝色;偏酸性的伊红能结合于碱性蛋白质,使之呈红色;中性蛋白质呈浅紫红色。
瑞氏染色对细胞结构染色较好,但有时对染色质着色不深,此类标本可加用吉姆萨(Giemsa)染料,称瑞氏-吉姆萨染色。
吉姆萨染色对细胞核染色效果好,故常用于细胞染色体检查、厚薄血膜镜检查疟原虫等。
镜下常见血细胞形态红细胞在染色良好的涂片中,血红蛋白结合伊红,红细胞呈粉红至红色,中央因双凹圆盘结构而呈现空白,平均直径7μm。
红细胞也常作为镜下评价血涂片染色质量和患者血红蛋白含量的参照物,如红细胞染色整体偏蓝,则常提示染液过碱,染液过酸时则红细胞颜色明显偏红;如红细胞颜色过淡、体积大小不均一,中央淡染区扩大,常提示缺铁性贫血。



一、实验目的1. 掌握血涂片的制备方法。
2. 了解血液细胞的形态和数量。
3. 熟悉显微镜的使用技巧。
二、实验原理血涂片是临床检验中常用的一种方法,通过将血液涂抹在载玻片上,经过染色、固定等步骤,使血液中的细胞在显微镜下呈现出清晰的形态。
通过观察血涂片,可以了解血液中细胞的数量、形态及分布情况,从而辅助诊断疾病。
三、实验器材1. 显微镜2. 载玻片3. 盖玻片4. 刺血针5. 酒精棉球6. 瑞氏染液7. 滴管8. 烧杯9. 镜台10. 玻片夹四、实验步骤1. 采血:在耳垂或指尖部位用酒精棉球消毒,用刺血针刺破皮肤,使血液自然流出。
2. 涂片:用载玻片沾取第二滴血液,将载玻片倾斜45度,用另一载玻片的一端将血液均匀涂抹在载玻片上,形成薄层。
3. 干燥:将涂好的血涂片放在空气中自然干燥。
4. 固定:用酒精棉球轻轻擦拭血涂片边缘,固定细胞。
5. 染色:将瑞氏染液滴在血涂片上,染色时间为5-10分钟。
6. 冲洗:用蒸馏水冲洗血涂片,去除多余染液。
7. 吸干:用吸水纸轻轻吸干血涂片上的水分。
8. 观察显微镜:将血涂片放在显微镜载物台上,先用低倍镜观察,再用高倍镜观察细胞的形态和数量。
五、实验结果与分析1. 低倍镜观察:在低倍镜下观察到红细胞、白细胞和血小板,红细胞呈两面凹陷的圆饼状,白细胞呈球形或椭圆形,有细胞核,血小板较小,形态不规则。
2. 高倍镜观察:在高倍镜下观察到红细胞的形态、白细胞的大小、细胞核的形态及血小板的特点。
3. 统计分析:统计血涂片中红细胞、白细胞和血小板的数量,并计算百分比。
六、实验讨论1. 实验过程中,血液涂抹的厚度要适中,过厚会导致细胞重叠,过薄则不易观察到细胞。
2. 染色时间不宜过长,以免细胞变形。
3. 观察时,应先在低倍镜下找到细胞分布均匀、染色良好的区域,再进行高倍镜观察。
4. 通过本次实验,掌握了血涂片的制备方法,了解了血液细胞的形态和数量,提高了显微镜的使用技巧。
七、实验总结通过本次实验,我们对血涂片的制备方法有了更深入的了解,掌握了血液细胞的观察技巧。
浙江省临床检验中心2009年第1次血细胞形态学室间质量评价由toyxj整理注:若看不清结构,可以适当放大或缩小图片比例进行观察。
2009103请报告箭头所指细胞的名称镰形红细胞外周血片瑞氏染色1000X2009104外周血片瑞氏一吉姆萨染色1000X2009105外周血片瑞氏一吉姆萨染色1000X 男性患者,34 岁。
广泛皮肤红斑2周入院,血常规WBC 23.5 X 109/L,其中淋巴:73%,Hb : 106 g/L , Pit : 110 X 109/L 浅表淋巴结可及,脾脏轻度肿大。
请报告箭头所指细胞的名称赛塞利细胞2009106外周血片瑞氏一吉姆萨染色1000X 男性患者,16 岁,咽喉肿痛, 发热5天,浅表淋巴结肿大,上肢有皮肤红斑,瘙痒。
血常规结果:WBC15.7 X 109/L,分类异常细胞43%, Hb133 g/L , Plt9180X 10 /L。
请报告箭头所指细胞的名称异型淋巴细胞男性患者,41岁,浙 江龙泉人,肝脏移 植后发热1个月, 脾脏轻微肿大,浅 表淋巴结未及,血 常规 WBC3. 9 X 109/L, Hb 93 G/L Pit 43 X 10 9/L 。
请报告箭头所指 细胞内容物的名 称组织胞浆菌2009107 骨髓片瑞氏一吉 姆萨染色 1000X 请报告箭头所 指细胞的名称火焰状浆细胞2009108 骨髓片 瑞氏一吉 姆萨染色1000X2009109骨髓片瑞氏一吉姆萨染色1000X男性患者,22岁, 部队战士,安徽芜• 湖人,不规则双峰型发热、纳差月』余。
体检:消瘦,4贫血貌,脾大质,软。
实验室检查三P 系减少。
请报告箭头所指物质的名称利杜体(利什曼原虫)2009110骨髓片瑞氏一吉姆萨染色1000X 请报告箭头所指细胞的名称巨红细胞请报告箭头所指细胞的名称2009111外周血片瑞氏一吉姆萨染色1000X2009112外周血片瑞氏一吉姆萨染色1000X晚幼红细胞请报告箭头所指细胞的名称Pelger-huet 粒细胞请报告箭头所指细胞的名称2009115外周血片瑞氏一吉姆萨染色1000X涂抹细胞2009116外周血片瑞氏一吉姆萨染色1000X 请报告箭头所指细胞的名称嗜多色性红细胞2009117骨髓片瑞氏一吉姆萨染色1000X 请报告箭头所指细胞内容物的名称Auer小体2009118骨髓片瑞氏一吉姆萨染色1000X 男性患者,46岁,体检时发现WB增高,淋巴细胞增高(Hb:137g/L,WBC:14 .9 X 109/L , N: 22% L:78%, Pit: 273 X 109/L ), 肝、脾、淋巴结无殊。

血涂片实验报告血涂片实验报告引言:血涂片实验是一种常见的临床检验方法,用于观察和分析血细胞的形态和数量,从而帮助医生判断患者的健康状况。
本次实验旨在通过对血涂片的制备和观察,了解血液中各类细胞的形态特征及其数量变化,进一步加深对血液疾病的认识。
实验步骤:1. 血液采集:使用无菌注射器从患者的指尖或静脉采集适量的血液样本,注意避免血液污染和交叉感染。
2. 制备血涂片:将采集到的血液样本滴在玻片上,利用另一块玻片将血液涂抹成薄膜,然后晾干。
3. 固定染色:将制备好的血涂片浸入甲醇中,固定血细胞的形态,然后再放入染色剂中,如吉姆萨染色液,使细胞成为可观察的颜色。
4. 镜检观察:将染好的血涂片放在显微镜下,通过调节镜头和光源,观察血细胞的形态和数量。
实验结果:在显微镜下观察血涂片,我们可以看到不同种类的血细胞以及它们的形态特征。
红细胞呈圆形或扁平的双凸形,中间凹陷,边缘光滑。
白细胞分为中性粒细胞、淋巴细胞、单核细胞、嗜酸性粒细胞和嗜碱性粒细胞等。
中性粒细胞具有多个核,细胞质内有颗粒状物质;淋巴细胞则呈圆形,细胞质较少,核浓染;单核细胞呈圆形或椭圆形,核偏心,细胞质较多。
嗜酸性粒细胞和嗜碱性粒细胞则带有颗粒状物质,分别呈酸性和碱性反应。
讨论:通过血涂片的观察,我们可以了解到血液中各类细胞的数量和形态特征,进而判断患者的健康状况。
例如,红细胞的形态异常可能提示贫血或其他血液疾病的存在,而白细胞的数量和比例变化则可能与感染、炎症或免疫系统的异常有关。
此外,血涂片还可以用于诊断一些特定的血液疾病。
例如,淋巴细胞的数量增多可能与淋巴细胞白血病有关,而中性粒细胞的数量增多则可能与感染或炎症有关。
嗜酸性粒细胞和嗜碱性粒细胞的数量增多则可能与过敏反应或寄生虫感染有关。
结论:血涂片实验是一种简单而有效的临床检验方法,通过观察和分析血细胞的形态和数量,可以帮助医生判断患者的健康状况和诊断一些特定的血液疾病。
通过本次实验,我们更加深入地了解了血液的组成和特点,为进一步研究和治疗血液疾病提供了基础。

血涂片实验报告引言血涂片实验是一项常用的临床诊断方法,通过观察血液中的细胞形态和数量变化,可以很大程度上反映出人体内部的疾病情况。
本文将分析血涂片实验的方法与意义,并通过实验结果展示其应用价值。
实验方法首先,需要从被试者的指尖或手臂处取血。
为了避免可能的感染,必须确保实验操作的无菌环境。
取血后,使用一根清洁的玻璃杆将血涂抹在载玻片上。
随后,通过顺着载玻片表面平行移动第二根载玻片,使血涂片得到适当的延展。
实验意义血涂片实验可以分析血液中的各种细胞,主要包括红细胞、白细胞和血小板。
通过观察这些细胞的形态、数量变化等指标,我们可以初步判断出体内是否存在贫血、感染、血液病等疾病。
此外,血涂片实验还能帮助病理学家进行癌症筛查,通过检测异常的细胞形态来发现癌症的早期病变。
红细胞的观察与分析红细胞是血液中数量最多的细胞,负责携氧和排除二氧化碳的功能。
通过计算红细胞的数量和观察其形态,可以初步判断出贫血等疾病。
在正常情况下,红细胞应该呈现出圆盘状,具有柔软的质地。
而当患者患有贫血时,红细胞形态会发生变化,如出现小细胞、巨幼细胞等异常情况。
白细胞的观察与分析白细胞数量和形态的改变可以反映出体内是否存在感染等疾病。
正常情况下,白细胞的数量应该在一定的范围内,一旦超标,则可能是由于感染或炎症等原因引起。
此外,白细胞的形态也可以提供一定的诊断信息,如中性粒细胞偏低可能暗示感染。
血小板的观察与分析血小板在血液凝结过程中起着重要的作用。
通过观察血小板数量以及其形态的改变,可以判断出体内是否存在出血倾向的情况。
正常情况下,血小板应该呈现出圆盘状,边缘平滑。
如果血小板数量过低或出现聚集现象,则病人可能面临出血风险。
实验结果分析在我们的实验中,我们发现了患者A的血涂片中出现了大量的嗜酸性粒细胞。
这可能意味着患者A正处于某种过敏反应或感染状态下。
进一步的检查显示,患者A患有哮喘,这也与嗜酸性粒细胞增多的结果相吻合。
此外,我们还观察到患者B的血涂片中存在大量的巨幼红细胞,这可能是由于B患有缺铁性贫血所致。


外周血涂片的显微镜检查上海市临床检验中心许蕾主要内容:一.概况二.红系正常及异常形态(大小,形态,结构,染色,其他)三.白系正常及异常形态(5种WBC及其他)四.巨核系正常及异常形态(血小板等)五.血液中寄生虫形态六.血液中其他异常形态一、概况外周血涂片(血象)镜检:血象中的血细胞主要来自骨髓及其他,所以血象检查对造血系统及其他系统疾病的诊断和鉴别非常重要。
血涂片镜检涉及到患者状态,采血、涂片、染色、经验等。
一、概况血涂片染色方法:1.瑞氏染色法;2.姬(吉)氏染色法:3.混合染色法:4.Romanowsky染色法*5.快速染色法:一、概况镜检法先10* 40* 100*(油)城垛式从体尾交界处向尾部进行镜检。
一、概况白细胞分类计数参考方法(中华人民共和国卫生行业标准WS/T246-2005 中华人民共和国卫生部发布2005-12-01实施)包括样本采集,血涂片制备,染色,有核细胞检查步骤和方法,对检验人员要求和考核等内容。
一、概况血象可反映下列情况:1.红细胞,(网织红细胞),白细胞,血小板大致数量,正常人血涂片1-3WBC/10-15PLT/200RBC,非抗凝血血小板应有聚集现象。
2.红系:观察有无有核红细胞,成熟红细胞有无大小,形态,结构(e.g. H-J body等),染色等异常。
3.粒系:观察各种粒系所占比例,有无幼稚细胞出现,有无病理形态出现(e.g. 中毒颗粒,空泡等)。
4.其他白细胞系统:观察各系所占比例,有无幼稚和异常形态结构的细胞(e.g. 异淋,浆细胞等)。
5.血小板:有无数量,大小,形态,染色,聚集性等的异常,有无巨核细胞。
6.有无寄生虫和其他特殊异常细胞(e.g. 疟原虫,癌细胞,破碎细胞等)。
二、红系正常及异常形态正常RBC :园盘形,φ6.7-7.7 (6-9)um ,淡红色,有中央淡染区,无核。
异常RBC 形态及相关疾病:一、大小异常1.RBC 生成加速。
2.MA,HA,急失血贫。
临床经验基础血涂片知识点
血涂片是一种观察血液细胞的方法,制备厚薄适宜、分布均匀、染色良好的血涂片是血液学检查的重要基本技术之一。
以下是临床经验基础血涂片知识点:
1. 瑞氏染料:由酸性染料伊红和碱性染料美蓝组成的复合染料,溶于甲醇后重新解离为带正电的美蓝和带负电的伊红离子。
2. 血涂片的制作:取末捎血一滴置于玻片的一端,左手持载玻片,右手以边缘平滑的推片的一端从血滴前方后移接触血滴,血滴即沿推片散开。
然后保持30-45度的夹角稳地向前移动,载片上保留下一薄层血膜。
3. 血细胞观察:通过显微镜观察血涂片中的红细胞、白细胞和血小板等血细胞的数量和形态,可以判断血液是否正常。
例如,观察白细胞的数量和形态可以判断是否存在感染;观察血小板数量和形态可以判断是否存在血小板减少或增多等异常情况。
4. 血型鉴定:通过观察血涂片中的红细胞上的抗原,可以确定ABO血型。
5. 细胞染色:为了更好地观察细胞内部结构、识别各种细胞及其异常变化,需要对血涂片进行染色。
常用瑞特染色法。
6. 仪器设备:Motic光学显微镜是常用的观察血涂片的仪器设备。
以上信息仅供参考,如果需要获取更准确的信息,建议咨询医生或相关专业人士。
血液涂片细胞学分析血涂片镜检是作为一名检验人员必备的技能,目前仪器无法替代。
摘自网上相关网站,整理如下,各位好好努力学习。
淋巴细胞(左),异型淋巴细胞(右)。
左边细胞胞质呈淡蓝色(略带灰)而没有中性颗粒,胞体也不大。
右边细胞的胞体大、胞质较深蓝且较多、染色质较粗,这些都是异淋的特点。
而早幼红细胞胞核圆形、染色质较细,核常居中,血片出现早幼红细胞的概率远远低于异淋。
从左到右,分别是中性分叶核粒细胞、单核细胞及中性杆状核粒细胞(伴巨幼样变)。
有时单核细胞的胞核也可呈杆状,但其胞质中不含中性颗粒(根据这点往往就能与中性粒细胞区别开来),且胞核染色质较疏松。
巨晚幼红细胞(含豪乔氏小体,也可能是双核)。
主要通过观察其胞质的特点,基本上就可断定是红系细胞,因为从中幼红细胞开始合成血红蛋白,这是红系细胞所特有的。
淋巴细胞(左)、典型的原始细胞(右,不含棒状小体)。
如果血片中出现原始细胞,我们不需要区分它是那系的,只要报原始细胞占多少即可。
中性杆状核粒细胞(含少许中毒颗粒,并见杜勒小体)。
杜勒小体有时不明显(淡蓝色,云雾状,边界不清楚),不仔细观察有时易被忽略成熟单核细胞。
其胞质中含有许多细小、淡紫红色的风尘样颗粒,胞核看似圆形、疏松,实际上有折叠。
幼稚单核细胞与成熟单核细胞经常较难区分,所以我们常常要结合周围伴随的细胞来辅助判断。
另外,根据这细胞胞质的特点是有点像巨系,但其胞核染色质及核形均不像.成熟淋巴细胞。
其胞核中有假核仁,这在成熟淋巴细胞中还是挺常见的,故应注意与幼稚、原始细胞鉴别。
后两者胞体大些、胞质更蓝,染色质呈颗粒状。
双核成熟淋巴细胞。
这个细胞比较难。
这在教材及参考书中几乎均未提及,但我们实际上偶尔也可观察到双核,这不代表这是病态淋巴细胞。
如何分析该细胞呢?根据细胞特点,说明这是个成熟血细胞,粒系可除外,主要考虑淋巴及单核细胞,其胞核染色质粗但无折叠,胞质也较蓝,这些特征都是符合。
上面的为中性晚幼粒细胞(其核有折叠、副染色质不明显,故还是归入晚幼阶段),其胞质中含有丰富的中性颗粒而呈淡红色。